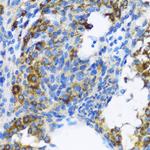
PTCH Antibody in Immunohistochemistry (Paraffin) (IHC (P))

Search
Invitrogen
PTCH Polyclonal Antibody
{{$productOrderCtrl.translations['antibody.pdp.commerceCard.promotion.promotions']}}
{{$productOrderCtrl.translations['antibody.pdp.commerceCard.promotion.viewpromo']}}
{{$productOrderCtrl.translations['antibody.pdp.commerceCard.promotion.promocode']}}: {{promo.promoCode}} {{promo.promoTitle}} {{promo.promoDescription}}. {{$productOrderCtrl.translations['antibody.pdp.commerceCard.promotion.learnmore']}}
图: 1 / 6
PTCH Antibody (PA5-87508) in IHC (P)

Please note: We are reviewing Western blot images included in the antibody testing data in our catalog, including those provided by third parties. Unless expressly labeled or annotated as “raw-unedited”, Western blot images included in the antibody testing data in our catalog may have been edited, optimized or otherwise adjusted for presentation.
产品信息
PA5-87508
种属反应
宿主/亚型
分类
类型
抗原
偶联物
形式
浓度
规格
纯化类型
保存液
内含物
保存条件
运输条件
RRID
产品详细信息
Immunogen sequence: THSGSDSSDS EYSSQTTVSG LSEELRHYEA QQGAGGPAHQ VIVEATENPV FAHSTVVHPE SRHHPPSNPR QQPHLDSGSL PPGRQGQQPR RDPPREGLW; Positive Samples: 293T, Mouse liver; Cellular Location: Membrane, Multi-pass membrane protein
靶标信息
This gene encodes a member of the patched gene family. The encoded protein is the receptor for sonic hedgehog, a secreted molecule implicated in the formation of embryonic structures and in tumorigenesis, as well as the desert hedgehog and indian hedgehog proteins. This gene functions as a tumor suppressor. Mutations of this gene have been associated with basal cell nevus syndrome, esophageal squamous cell carcinoma, trichoepitheliomas, transitional cell carcinomas of the bladder, as well as holoprosencephaly. Alternative splicing results in multiple transcript variants encoding different isoforms. Additional splice variants have been described, but their full length sequences and biological validity cannot be determined currently.
仅用于科研。不用于诊断过程。未经明确授权不得转售。
生物信息学
蛋白别名: etID309849.2; FLJ26746; FLJ42602; HGNC:9585; mesenchymal dysplasia; OTTHUMP00000021709; OTTHUMP00000021710; patched; Patched 1; patched homolog 2; patched1; Protein patched homolog 1; PTC; ptc-1; PTCH protein -3; Ptch1 protein +12b; RP11-435O5.3
基因别名: A230106A15Rik; mes; Ptc; Ptc1; Ptch; Ptch1; Ptch2
UniProt ID: (Mouse) Q61115
Entrez Gene ID: (Rat) 89830, (Mouse) 19206




